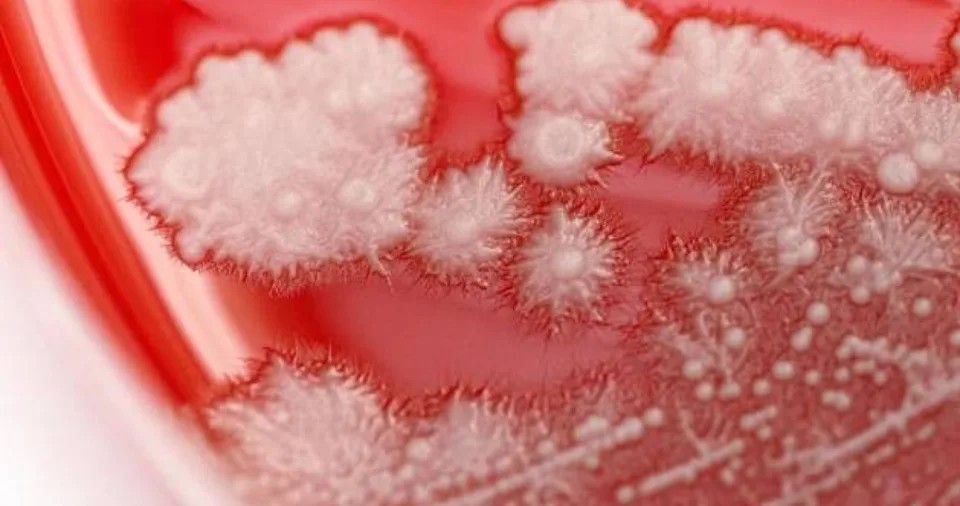

快訊
- 快訊/日本山梨縣5.6地震、最大震度6弱 富士山腳飯店「左右猛搖15秒」
- OpenAI延後上市、蘋果漲價持績發威 美股三大指數開盤走跌
- 快訊/中國輕型飛機失事 撞上北京最高樓「中國尊」、當局大舉封鎖現場
- 【委內瑞拉強震】罹難者暴增至589人 多國出動搜救隊相助
- 【一文看懂】歐洲比台灣還熱!造成逾200死熱浪的「歐米茄阻塞」是什麼?
- 愛爾麗診所涉偷拍7年!總裁常如山遭求刑14年 移審法院「哭撇犯罪」續押3月
- 不服遭認定職場霸凌!楊珍妮六點聲明反擊:少數片面之詞欠缺正當程序
- 國民黨再轉彎!藍委「鞭刑公投」敗部復活 下週提案逕付二讀
- 經濟部A+通過3項補助逾3.1億元 強化6G通訊、先進封裝設備自主能量
- 豪雨2天半全台水庫入流近2.5億噸 南化滿庫、曾文半飽 員山子開始分洪
- 南韓首爾祭新規:160Wh以上鋰電池禁入地鐵站 7/01實施
- 八仙塵爆11周年!最高院判觀光署、新北市府有責任 國賠家屬2100萬元確定
- 永豐金決議辦理現增2百億! 強化證券子公司資本結構
- 公文系統遭爆用「中國技術」 食藥署看到報導才知:若屬實就重新辦理採購
- 顏慧欣疑遭霸凌案 政院公布調查:兩項霸凌行為成立、楊珍妮去留卓揆下週決定
- 【台電股東會】小股東虧不如買「台積電」 曾文生:好好經營讓公司價值「多1字」
- 南韓前第一夫人金建希被控收賄喬事 一審遭判7年
- 【委內瑞拉強震】女子受困逾24小時獲救!意識清楚憶當下「緊抓門框、手指都骨折了」
- 打筆戰輸學長姐竟掰「被盜帳號」!菜鳥法官被送懲戒道歉了 求輕罰「申誡」
- 景氣熱絡燈號連6紅 國發會:出口與投資動能續強 留意關稅與地緣政治變數
感冒亂吃抗生素!男喉痛一個月沒好 醫檢查竟「長滿雪花」
2025-11-09 15:58 / 作者 陳康宜

喉嚨痛示意圖。取自pexels
感冒自行服用抗生素,小心狀況愈來愈糟。中國一名男子喉嚨痛,因為工作忙碌,便自行購買抗生素服用,沒想到症狀反變嚴重,就醫時發現喉嚨感染真菌,布滿白色斑點。根據中國央視網等報導,浙江省寧波市36歲張姓男子(化名)從事銷售工作,經常熬夜、出差,生活作息不規律,近日出現喉嚨痛,便自行買來抗生素吃下,沒想到一個月過去,病情不但沒改善還惡化,這才到寧波市北侖區第二人民醫院就診。
耳鼻喉科主任鄔忠偉進行喉鏡檢查後,發現張男咽喉有一層白茫茫的「雪花」,得知張男經常自行服用抗生素,確認為真菌感染,禍首則是白色念珠菌。
患者咽喉後壁布滿白色斑點,確診為真菌感染。翻攝自微博
鄔忠偉表示,抗生素雖會殺死病菌,但會不分青紅皂白地把口腔裡的「好菌」、「壞菌」一律殺光,讓白色念珠菌有機可乘,加上張男處於高壓狀態也易使免疫力下降,因而引起感染。張男停用抗生素,並對症下藥後,喉嚨痛明顯緩解,白色斑點也逐漸消退。
鄔忠偉提醒,雖然7成急性咽喉痛與病毒感染有關,但仍要確認病因才考慮使用抗生素,若是有相關症狀還是應該就診。
根據高醫醫訊,念珠菌是一種真菌(黴菌),是人體常見的共生菌種,正常分佈於口腔、腸胃道及生殖泌尿道。喉嚨念珠菌症多見於嬰兒、孕婦、老人、營養不良、重症患者等免疫力較低的人身上。
最新more>
熱門more>
- 全民抓電子煙!國健署擬訂獎勵辦法 未來檢舉違法電子煙有獎
- 年僅20多歲!女主持人不敵卵巢癌病逝 當「大體老師」遺愛人間
- 郭明鑑董事兼職風暴 蔡鎮宇持續開轟 金管會回應:有公司治理疑慮、已派員金檢
- 美光財報好到炸裂! 陸行之:記憶體是否短多長空看這些訊號
- 國泰投信利害關係人風暴未完! 金管會:要求國泰投信全面清查
- 世足賽》1-0完封南韓 南非隊史首次晉級淘汰賽
- 【一文看懂】歐洲比台灣還熱!造成逾200死熱浪的「歐米茄阻塞」是什麼?
- 【委內瑞拉強震】罹難者暴增至589人 多國出動搜救隊相助
- 川普遲未公布對台軍售案 美亞太助卿:不會取決於美中談判
- 人倫悲劇!不忍母親長照壓力 台中男涉加工自殺罪遭起訴

